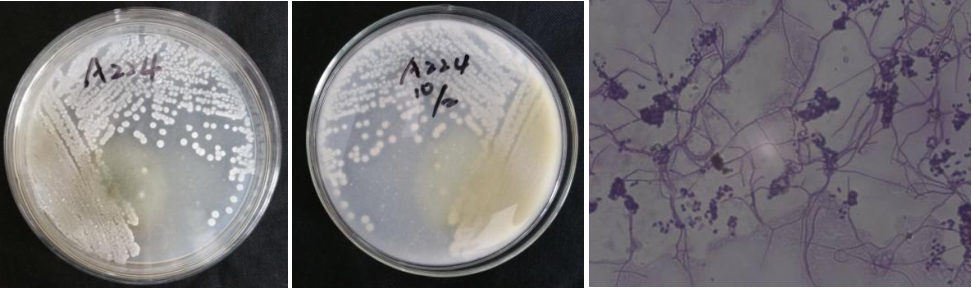

Loading...
| StrainNO | A224 |
| Classification | Streptacidiphilus |
| 16s rDNA sequence | TTTGATCCTGGCTCAGGACGAACGCTGGCGGCGTGCTTAACACATGCAAGTCGAACGGTGAAGCCCTTCGGGGTGGATCAGTGGC GAACGGGTGAGTAACACGTGGGTAATCTGCCCTGCATTCTGGGACAAGCCTTGGAAACGAGGTCTAATACCGGATACGACGCATC TCCGCATGGGGTGTGCGTGGAAAGCTCCGGCGATGCAGGATGAACCCGCGGCCTATCAGCTTGTTGGTGGGGTGATGGCCTACCA AGGCGACGACGGGTAGCCGGCCTGAGAGGGCGACCGGCCACACTGGGACTGAGACACGGCCCAGACTCCTACGGGAGGCAGCAGT GGGGAATATTGCACAATGGGCGAAAGCCTGATGCAGCGACGCCGCGTGAGGGATGACGGCCTTCGGGTTGTAAACCTCTTTCAGC AGGGAAGAAGCGCAAGTGACGGTACCTGCAGAAGAAGCACCGGCTAACTACGTGCCAGCAGCCGCGGTAATACGTAGGGTGCGAG CGTTGTCCGGAATTATTGGGCGTAAAGAGCTCGTAGGCGGCTTGTCGCGTCGGATGTGAAAGCCCGGGGCTTAACTCCGGGTCTG CATTCGATACGGGCAGGCTAGAGTGTGGTAGGGGAGATCGGAATTCCTGGTGTAGCGGTGAAATGCGCAGATATCAGGAGGAACA CCGGTGGCGAAGGCGGATCTCTGGGCCATTACTGACGCTGAGGAGCGAAAGCGTGGGGAGCGAACAGGATTAGATACCCTGGTAG TCCACGCCGTAAACGTTGGGAACTAGGTGTGGGTCACATTCCACGTGGTCCGCGCCGCAGCTAACGCATTAAGTTCCCCGCCTGG GGAGTACGGCCGCAAGGCTAAAACTCAAAGGAATTGACGGGGGCCCGCACAAGCAGCGGAGCATGTGGCTTAATTCGACGCAACG CGAAGAACCTTACCAAGGCTTGACATATACCGGAAACGTGCAGAGATGTACGCCCCCTTGTGGTCGGTATACAGGTGGTGCATGG TTGTCGTCAGCTCGTGTCGTGAGATGTTGGGTTAAGTCCCGCAACGAGCGCAACCCTCGTTCTGTGTTGCCAGCGGGTTATGCCG GGGACTCACAGGAGACTGCCGGGGTCAACTCGGAGGAAGGTGGGGACGACGTCAAATCATCATGCCCCTTATGTCTTGGGCTGCA CACGTGCTACAATGGCCGGTACAATGAGCTGCGATACCGCGAGGTGGAGCGAATCTCAAAAAGCCGGTCTCAGTTCGGATTGGGG TCTGCAACTCGACCCCATGAAGTCGGAGTTGCTAGTAATCGCAGATCAGCAGTGCTGCGGTGAATACGTTCCCGGGCCTTGTACA CACCGCCCGTCACGTCACGAAAGTCGGTAACACCCGAAGCCGGTGGCCTAACCCGTAAGGGACGCTAACCCGTAAGGGACG |
| Strain Morphology Photos | |
| Morphological Description | Mycelia branch;there are septa not broken;there are straight short filaments like spore filaments curved or spiral spore filaments;spores are larger;spindle or oblong spore piles milky white;back bean |